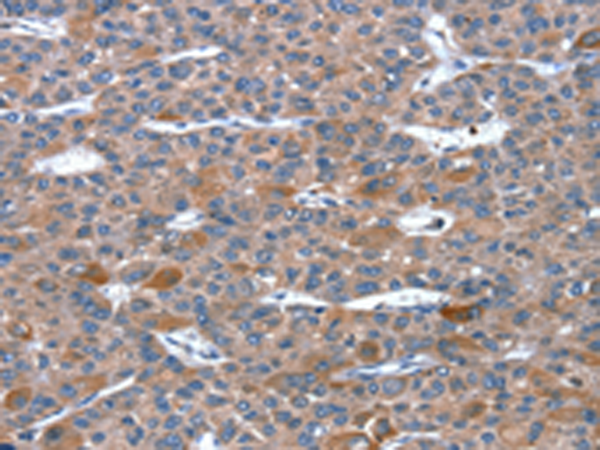
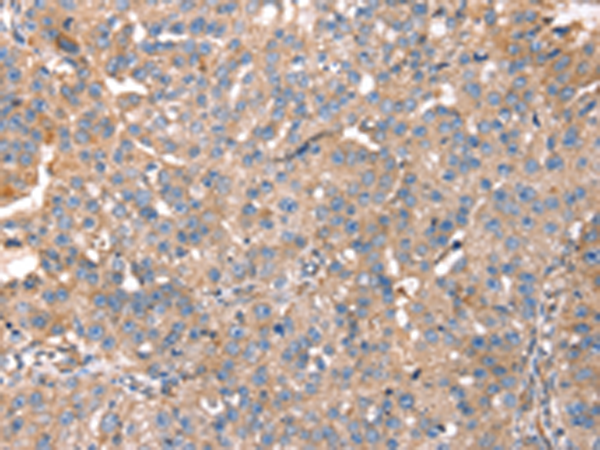

-
分类: 科研抗体货号: P08707别名: ARHE; Rho8; RhoE; memB应用: IHC反应种属: Human, Mouse, Rat
-
分类: 科研抗体货号: P08686别名: GISP; RELP; REG-IV应用: IHC反应种属: Human
-
分类: 科研抗体货号: P08699别名:应用: WB反应种属: Human
-
分类: 科研抗体货号: P08705别名: RIP5; RIPK5; CAKUT1; DustyPK; HDCMD38P应用: WB,IHC反应种属: Human
-
分类: 科研抗体货号: P08685别名: P19; PSP; PTP; REG; ICRF; PSPS; PSPS1应用: WB反应种属: Human
-
分类: 科研抗体货号: P08695别名: RS11应用: IHC反应种属: Human
-
分类: 科研抗体货号: P08703别名: RIP; RIP1; AIEFL; IMD57; RIP-1应用: WB,IHC反应种属: Human, Mouse
-
分类: 科研抗体货号: P08684别名: Rec8p; REC8L1; HR21spB应用: WB,IHC反应种属: Human, Mouse
-
分类: 科研抗体货号: P08694别名: GAP; S914; HA117应用: IHC反应种属: Human, Mouse
-
分类: 科研抗体货号: P08702别名: RIL应用: WB,IHC反应种属: Human, Mouse, Rat

鄂公网安备42018502007531号
鄂公网安备42018502007531号

